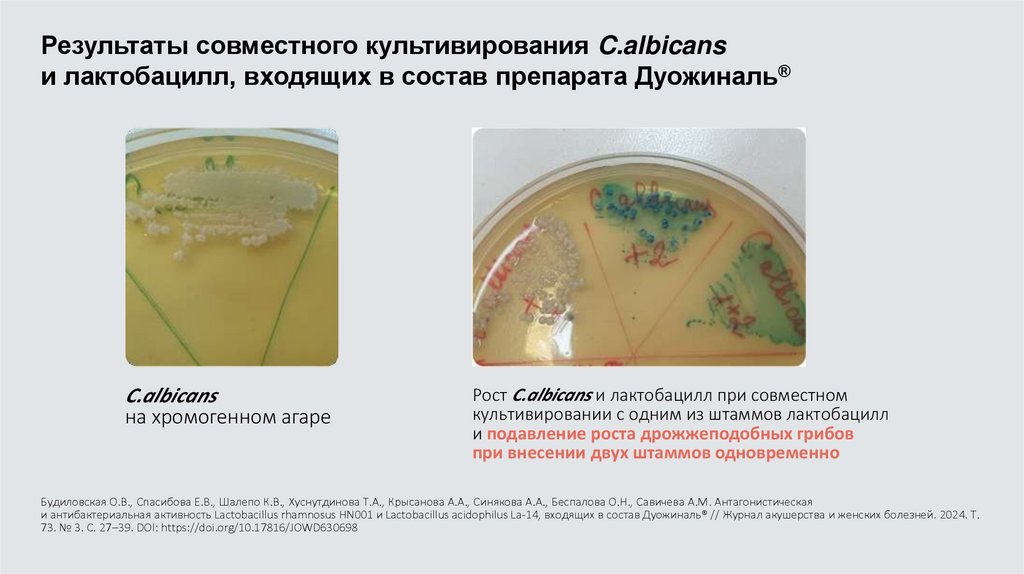

Similar presentations:
Поле боя – женская консультация!
1. Поле боя – женская консультация!
Алгоритмы ведения пациенток спатологическими вагинальными
выделениями
Михайлюкова В.А.
к.м.н., доцент кафедры
акушерства и гинекологии СЗГМУ им. И.И. Мечникова
2. Заболевания, сопровождающиеся патологическими выделениями из влагалища
Бактериальныйвагиноз
Вульво-вагинальный
кандидоз
Смешанный
вагинит
Хроническая
герпетическая инфекция
?
?
Воспалительные заболевания
органов малого таза
Специфический
вагинит/цервицит
Цитолитический
вагиноз
Т.Н. Бебнева, Т.А. Добрецова. Смешанные вагинальные инфекции: новая идеология // Status Praesens.-2016.-№2.
Аэробный
вагинит
3. Нормальная влагалищная жидкость (1-5 мл/сут)
Транссудат сосудов стенкивлагалища
Секрет желез шейки матки и
преддверия влагалища
Десквамированный эпителий,
лейкоциты, микроорганизмы
4. Пациентка на приеме – основные задачи врача!
Ок азать медицинскую помощь поизбавлению от симптомов
заболевания при первом же визите.
Обследовать женщину и определить
причину заболевания.
Назначить эмпирическую терапию до
получения результатов
лабораторных тестов.
В.Е. Радзинский. Операция «Ликвидация». Патологические вагинальные выделения: выбор тактики: Информационный бюллетень. – М.: Редакция журнала StatusPraesens, 2022. – 16с.
5. Клинические проявления острого воспалительного процесса нижних отделов гениталий
Жалобы:• Патологические выделения из половых путей (70%).
• Неприятный запах выделений (20%).
• Жжение (12%).
• Боль и зуд во влагалище или его преддверии (72%).
• Диспареуния.
Гинекологический осмотр:
• Отечность, гиперемия слизистой оболочки влагалища.
• Петехиальные кровоизлияния и поверхностные эрозии
слизистой оболочки влагалища.
• Обильные выделения.
Инфекционно-воспалительные заболевания женских половых органов / И.В. Кузнецова, А.П. Никонов, Т.А. Джибладзе, А.В. Белова, Т.Н. Бебнева, М.В. Беришвили. 2-е изд., доп. – М., 2022. – 144 с.
6. Трудности диагностики бактериального вагиноза
Критерии Аmsel:• Патологические выделения
• pH ≥4,5
• Аминный тест
• Ключевые клетки
Хранение 10% раствора КОН в кабинете
врача не предусмотрено,
рН-метрия повсеместно не внедрена!
Биоценоз влагалища. Норма. Нарушения. Восстановление. Радзинский В.Е., Савичева А.М., Воробьев С.В. и др.; Под ред. В.Е. Радзинского, А.М.
Савичевой. - М., 2023. – 380 с.
7. Кольпотест
Зеркало влагалищноеРадзинского-Занько рНиндикатором
8.
рН и микрофлора влагалищаpH 3.8-4.4
pH 4.5-6.0
pH > 6.0
Нормальная лактофлора
Дрожжеподобные грибы
Отсутствие или малое количество лактобактерий
Бактериальный вагиноз
Смешанная флора
Трихомониаз
Повышение количества лейкоцитов
Нет лактобактерий
Атрофия эпителия/синильный вагинит
Разрыв околоплодной оболочки
О.А.Громова, И.Ю.Торшин, Е.В.Гарасько. Физиологические и молекулярные механизмы топического воздействия аскорбиновой кислоты на вагинальную флору. Гинекология. №4 с. 24-30
9. Лабораторные исследования
Вс е м п а ц и ен тк ам и с к л юч е ние а бс олютн ыхп ато ген ов :
M . G e n i t al iu m ,
T. Va g i n a li s,
C . Tr a c ho mati s,
N . G o n o rrh oea e,
М и к р о ск о пия м аз к о в :
Н ат и вн ы х,
О к р а ш ен ных .
Н е р е к о м е н дова но к ул ьт ур а л ь н о е и с с ледо ва ние
( к р о м е р е ц и ди вирую щ их п р о цесс о в ).
И с с ледо ва ние м оч и н е р е к о м е нд уется .
Ци тол о г ич е ск ое и с с л ед овани е.
РОАГ 2024
10. Варианты цитологического заключения
11. Цитологическое исследование
12. Микроскопия мазка
Э п и т ел и а л ь н ы е к л е т к и ( е с т ьли глубокие сл ои).
Полиморфноядерные
лейкоциты.
О т н о ш е н и е э п и т ел и а л ь н ы х
к леток и лейк оцитов.
Микрофлора, в том числе
патогенная.
13.
Российские клинические рекомендации по лечениювоспалительных и дисбиотических процессов в нижних отделах
гениталий
14. Реалии современности: при каком заболевании применяется указанная схема?
Рецидивирующийвагинит
15. Причины рецидива неспецифических заболеваний влагалища
1. Сохранение факторов риска2. Нерациональная антибактериальная терапия и
снижение чувствительности микрофлоры
3. Формирование бактериальных пленок
4. Щелочная среда во влагалище после лечения
(pH>4,5)
Swidsinski A, Mendling W, Loening-Baucke V, et al. Adherent biofilms in bacterial vaginosis. Obstet Gynecol 2005;106:1013-23.
16. Перезагрузка вагинального микробиома: смена парадигмы
I этапАНТИМИКРОБНАЯ
ТЕРАПИЯ
подавление УПФ,
лактобактерий
II этап
ВОССТАНОВЛЕНИЕ
ЛАКТОБАКТЕРИЙ
*УПФ – условно-патогенная флора
В.Е. Радзинский, И.М. Ордиянс. Двухэтапная терапия вагинальных инфекций. М.: Редакция журнала Status Praesens, 2012.-16 с.
17. Препараты второго этапа лечения (перезагрузка влагалищного биотопа)
В каком клиническом протоколе прописана необходимость 2 этапа?Органические
кислоты
Пробиотики
Профилактика
рецидива
Кудрявцева Л.B., Ильина Е.Н., Говорун B.М., Минаев В.И., Зайцева С.B., Лилова Е.В., Баткаев Э.А.
Бактериальный вагиноз (Пособие для врачей). — М., 2001.
18.
Диагностика дисбиоза влагалища с ранних сроков беременностиможет быть использована в качестве предиктора
преждевременных родов (ПР)
По данным мета-анализа 2020 г
у женщин с нормальным вагинальным
микробиомом риск развития ПР
на 75% ниже
Именно отсутствие лактобацилл,
а не бактериальный вагиноз, является
фактором риска ПР
Результаты данного мета-анализа могут послужить основой ранней диагностики (с
1 триместра) снижения количества лактобацилл, что в будущем может снизить
показатели ПР
Kosti I, Lyalina S, Pollard KS, Butte AJ and Sirota M (2020) Meta-Analysis of Vaginal Microbiome Data Provides New Insights Into Preterm Birth. Front. Microbiol. 11:476. doi: 10.3389/fmicb.2020.00476
19. Пример развития «акушерского» АФС
- С 2017 года получает низкие дозы аспирина (75мг/сут)
- ВМК – с Метафолином и ДГК
- ЗГТ L-тироксином® 100 мкг/сут.
Пример развития
«акушерского» АФС
П е р во р од я ща я 3 9 л ет с ОА ГА :
2 0 1 2 год н е с о с то я в ш и й с я в ы к и д ы ш 5 / 6 н ед ель с
в ы с к а бли ва н и е м п ол о с т и м ат к и ;
2 0 1 6 год а н э мб р и о н и я с в ы с к а бли ва н и е м п ол о с т и
м ат к и ;
2 0 1 8 год с а м о п р о и з воль н ы й в ы к и д ы ш 5 / 6 н ед ель с
в ы с к а бли ван и ем п ол о с т и м ат к и .
В ы я вл е н ы ге н ет и ч е с ки е п ол и м о р фи з м ы ,
а с с о ц и и р о ва н н ы е с п ат ол о г и е й ге м о с таза ( м ут а ц и и
н и з к о го р и с к а ) .
Го м о ц и с те и н 7 , 6 9 м к м ол ь / л.
А н т и ф о с фоли п и дн ы е а н т итела от р и ц атель н ы е .
И з б ы точ н ы й ве с ( И М Т = 2 6 ) , C D I I т и п а , Х р А И Т
( г и п от и р е оз) .
20. Осложнение беременности – ИЦН в 19/20 недель на фоне смешанного вагинита
На значения второго триместра:Компрессионный трик отаж
ВМК с ДГК во время завтрак а
Утрожестан® 200 мг утром и
вечером интравагинально
Кардиомагнил® 7 5 мг вечером
перед сном
К л е к с а н ® 0 , 4 п о д к о ж н о е ж е д н е в го
И н с ул и н о т е р а п и я
L-тироксин® 100 мкг/сут утром
натощак
21. Лечение ИЦН
Ус т а н о в к а РА П п о с л е с а н а ц и ивл а га л и ща
У т р ож е ста н ® п о 2 0 0 м г
и н т а ва г и н а ль н о п е р ед с н о м д о 3 4
н ед ель б е р е м е н н о с т и
ВМК с ДГК и витамин Д по 2000
М Е / с ут д о р од о в
Эпизод кровомазания в 33/34 недели и зуд НПО,
Отрицательной динамики ИЦН по УЗИ не выявлено,
Данных за отслойку плаценты не получено,
Замена Лактагеля® на Лактожиналь® по 1 свече в день на 2
недели.
Клексан® и Кардиомагнил® продолжены в прежнем объеме.
К а рд и о м а г н и л ® 7 5 м г п е р ед с н о м д о
3 6 н ед ель б е р е м е н н о с т и
К л е к с ан ® п о 0 , 4 м л п од к ож н о д о
р од о в
L - т и р о к с и н ® п о 1 0 0 м к г / с ут д о р од о в
И н с ул и н оте р а п и я
р Н - м ет р и я ( и с ход н о – 5 , 5 ) ,
п од к и с ле н и е п о т р еб о ва н и ю
Л а к т а гель ® .
22. Алгоритм действий при ИЦН
Протокол «ИЦН», 202423.
ТРИбиотический эффект Лактожиналя, достигнутый особойметодикой производства
ПРЕбиотик:
Лактозы моногидрат питательная среда
для Лактобактерий
LCR3
ПРОбиотик:
Лактобактерии LCR
• Способствуют
восстановлению
местного иммунитета3
• Нормализуют pH3
• Формируют
защитные биопленки2
ПОСТбиотик:
метаболиты
лактобактерий LCR
(«ассистенты
антибиотиков»)
ингибируют рост
патогенов (Candida,
Gardnerella, Prevotella)2,4
1. Adrien Nivoliez. Influence of manufacturing processes on cell surface propertiesof probiotic strain Lactobacillus rhamnosus Lcr35. –Appl Microbiol Biotechnol (2015) 99:399411; 2. Coudeyras S. et al. Infectious Diseases in Obstetrics and Gynecology. 2008.
Vol. 2008, Article ID 549640, 5 pages ; 3. Инструкция по медицинскому применению препарата Лактожиналь ; 4. Савичева А. М., Рыбина Е. В. Акушерство и гинекология. 2014; №7; С. 79–83.
24.
LCR в составе Лактожиналь вырабатываютмолочную кислоту в 6 раз сильнее, чем обычные
лактобактерии
Синтез молочной кислоты штаммом LCR
(препарат Лактожиналь®)
Nivoliez A., Camares O., Paquet-Gachinat M. Infl uence of manufacturing processes on in
vitro properties of the probiotic strain Lactobacillus rhamnosus Lcr35®. Journal of
Biotechnology. 2012. 160. P. 236–241.
Савичева А. М., Рыбина Е. В. Исследование In Vitro роста, размножения, антибиотикорезистентности,
конкурентных взаимоотношений штамма Lactobacillus casei rhamnosus. «Акушерство и гинекология» 2014, №7. С. 79–83.
Лактожиналь способствует нормализации
pH уже в течение первых суток применения
Изменение pH питательной среды при
культивировании LCR (препарат Лактожиналь®)
25.
Лактобактерии LCR, входящие в состав Лактожиналя,одобрены и рекомендованы ведущими российскими
и зарубежными ассоциациями в области гинекологии
и дерматовенерологии в качестве 2 этапа терапии
вагинальных инфекций (БВ и ВВК)
Клинические
рекомендации МЗ
РФ 2022 г. по БВ*
Министерство
здравоохранения
Канады
Междисциплинарная
ассоциация
специалистов
репродуктивной
медицины
РОАГ – российское
общество
акушеровгинекологов
Совет экспертов
ЮСТИ
с международным
участием
55
26.
27. Пример «ранней» ИЦН
4 0 л ет, бе р ем е нно сть 1 - яп о с л е 5 - й п о п ы тк и Э КО
( т руб н ы й ф а к то р ),
Се р к л я ж ш/ м н а 1 4 - й
н ед ел е И ЦН п р и п е р во м
с к р и н инге ( 1 2 /1 3
н ед ел ь ),
Го с пи тал из аци я в Г П Ц в
2 3 / 2 4 н ед ел и с э п и зод ом
к р о во м аз ани я.
28. Лечение бактериального вагиноза
рН=5,5;Назначено «програмированное подкисление»;
Целевой показатель рН=4,8-4,5;
Зуд влагалища и творожистые выделения через 2 недели подкисления,
использован Залаин® в виде влагалищного суппозитория однократно,
затем Лактожиналь® по 1 свече на 21 день.
29.
Двухэтапная терапия с препаратом Лактожиналь®снижает риск БВ и ВВК1,2
По 2 капсулы
7 дней
при БВ
По 1 капсуле
21 день
при ВВК
Патологические
выделения из влагалища
Противомикробная
терапия
Нормализация
микрофлоры
Снижение дискомфорта. Надежная защита от рецидивов БВ и ВВК1,2
1. Провоторова Т. В. Российский вестникакушера-гинеколога, №4, 2014, стр. 87–94.
2. Башмакова Н. В. и др. Акушерство игинекология. 2017; 6: 136–4.
23
30.
Цервикометрияв 28 и 31 недели
беременности
Цервикометрия в 33-34 недели без
отрицательной динамики.
Микронизированный прогестерон
отменен в 34 недели
беременности.
В 37 недель направлена на снятие
шва шейки матки..
Оперативные роды в 39 недель
(Упорная слабость родовой
деятельности, отсутств ие эффекта
от родоусиления) – М-3620 мг/52
см.
31. Как действуют лактобактерии LCR в отношении Candida?
• Лактобактерии LCR являются антагонистами дрожжеподобных грибов рода Candida;• LCR конкуруют с грибами рода Candida за рецепторы на эпителиоцитах влагалища и секретируют
антифунгальные вещества – супернатанты;
Супернатанты – это комплекс всех химических веществ (активных метаболитов),
синтезируемых лактобактериями, который способствует угнетению роста и элиминированию
других микроорганизмов, включая грибки рода кандида.
Инструкция по медицинскому применению препарата Лактожиналь
32.
Первое многоцентровое наблюдательное сравнительное исследованиеодноэтапной и двухэтапной терапии БВ и ВВК у беременных
В. Е. Радзинский, И. Б. Манухин, В. Е. Балан, И. В. Сахаутдинова
Пациентки с рецидивами БВ
Пациентки с рецидивами ВВК
0%
рецидивов
БВ и ВВК
при применении
Лактожиналя®
вторым этапом
Только противомикробная терапия
Только противомикробная терапия
Радзинский В. Е., Манухин И. Б., Ордиянц И. М., Балан В. Е., Тихомирова Е. В., Сахаутдинова И. В., Зулкарнеева Э. М. Эффективность восстановления вагинальной микробиоты после противомикробной терапии бактериального
вагиноза и вульвовагинального кандидоза у беременных (по результатам многоцентрового проспективного неинтервенционного сравнительного исследования). РМЖ. Мать и дитя. 2021; 4 (3).
33. Пациентка 21 года на осмотре с жалобами на эпизоды легкого зуда во влагалище (практикует оральный секс)
Пациентка 21 года на осмотре с жалобами наэпизоды легкого зуда во влагалище
( п р а к т и к уе т о р а л ь н ы й с е к с )
Микроскопия мазка не проводилась!
34. После лечения жалобы на постоянный зуд влагалища и зеленые выделения из влагалища
35. Лечение
Флюконазол 150 мг 1 раз в неделю на 6месяцев.
Витамины группы В 2 -3 месяца.
Галавит ® рек тально по 100 мг на к урс 20
суппозиториев .
Макмирор к омплекс ® по 1 свече на ночь во
влагалище 8 дней, затем Лактожиналь ®
местно перед сном 21 день.
Для профилактики рецидива после
менструации: Д уожиналь ® по схеме:
П о 1 к а п сул е 1 0 д н е й е ж е м ес я ч н о 6 м е с я ц е в .
36. Микроскопия мазка
Мазок взят на 2 стекла.Оценивается натив ны й
и окрашенны й по Граму
варианты.
37. Отдаленный результат по окончании приема Дуожиналя® и Флюконазола
Отдаленный результат поокончании приема
Дуожиналя ® и Флюконазола
Мазки взяты через 7 месяцев первого контроля
лечения
38.
Пробиотики для поддержания гомеостаза вагинальной микробиотыи профилактики рецидивов вагинальных инфекций
Пробиотик( Lactobacillus spp.)
способ применения
пероральный
интравагинальный
Для восстановления количества лактобактерий в вагинальном тракте применяются пробиотики,
содержащие разные виды и штаммы Lactobacillus, вводимые перорально или интравагинально
YueHan and Qing-lingRen
Does probiotics work for bacterialvaginosis and vulvovaginal candidiasis, Elsevier 2021
1
6
39.
Инструкция (информация) по применению биологическиактивной добавки к пище Дуожиналь®
Лактобактерии могут использоваться для восстановления и поддержания нормальной
микрофлоры, pH влагалища и кишечника, а также для восстановления местного иммунитета
при следующих состояниях:
при дисбактериозах влагалища (нарушениях баланса вагинальной микрофлоры) в том числе
бактериальный вагиноз,неспецифический вульвовагинит вагинит,включая аэробный вагинит).
При вульвовагинальном кандидозе и смешанных вагинальных инфекциях.
Важно! При рецидивирующих состояниях,требующих коррекции микрофлоры, возможно
применение перорального пробиотика совместно с интравагинальным.
При терапии местными и системными противомикробными препаратами и противовирусными
препаратами, цитостатиками, кортикостероидами.
При использовании контрацепции.
Во время или после антимикробной терапии, противовирусной терапии
урогенитальных инфекций и заболеваний передающихся половым путем
(гонорея,хламидиоз,урогенитальный герпес,папиломовирусная инфекция).
При атрофическом вульвовагините.
40.
Свойства пробиотика Дуожиналь® за счет уникальнойкомбинации двух штаммов лактобацилл
2
1
7
Разрушение
патогенных
биопленок
3
Продукция
перекиси водорода
Доказанная
способность
колонизировать
влагалище
Нормализация pH влагалища
за счет продукции молочной кты
Lactobacillus
acidophilus LA-14
4
6
Подавление роста
патогенов
5
Способность
к адгезии к
эпителию
влагалища
Продукция
бактериоцинов
Lactobacillus
rhamnosus HN001
41.
При совместном культивировании штаммовLactobacillus rhamnosus HN 001 и Lactobacillus acidophilus la-14
происходит ингибирование основных возбудителей
Бактериального вагиноза и аэробного вагинита
(результаты исследования in vitro)
Lucia Bertuccini, Rosario Russo, Francesca Iosi1 and Fabiana Superti. Effects of Lactobacillus rhamnosus and Lactobacillus acidophilus on bacterial vaginal pathogens. International Journal of
Immunopathology and Pharmacology 1–5, 2017
42. Пациентка Г., 22 лет
Выявлен хламидийный цервицитПациентка Г.,
22 лет
Д о о с е н и 2 0 2 4 ВВК н е б ол е е 2 - х р аз в
год , л еч е н и е вл а га л и щны ми
п р е п ар ата м и н а о с н о ве азол о в с
п ол ожи тель н ым э ф ф е к том .
В о к т я б р е 2 0 2 4 год а л еч е н ие
хл а м и д и й ного це р ви ц ита.
П о с л е а н т и бак тери аль н ой те р а п ии
р е ц и д ивы ВВК еж е м еся ч но.
Б е с п о к оит ц и к л и ч е ск а я м а с та лги я з а
7 - 1 0 д н е й д о м е н с труа ции .
43. Обследование перед назначением лечения
За неделю до приема провелалечение влагалищными таблетками
Клотримазола® в течение 6 дней с
положительным эффектом
44. Лечение пациентки
Макмирор комплекс ® во влагалище передсном на 8 дней для эрадикации возбудителей.
Лактожиналь ® во влагалище перед сном на 21
Лечение
пациентки
день в качестве второго этапа по
восстановлению микрофлоры.
В к ачестве противорецидивной терапии:
Флюконазол по 150 мг 1 раз в неделю на 6 месяцев
Капсулы Д уожиналь ® перорально по одной в день на 10
дней ежемесячно в течение полугода.
рН - 4,8
45.
Дуожиналь® может быть рекомендован пациенткам с частыми рецидивамивагинальных инфекций совместно
с интравагинальным пробиотиком Лактожиналь®
68
Инструкция по медицинскому применению препарата Лактожиналь ®; Листок-вкладыш к БАД Дуожиналь®.
46. А есть ли ВВК?
4 3 год а , н е к ур и т, Ри ге ви д о н с 2 0 1 9 ( Г Э ).ХрУГИ методом ПЦР не
обнаружено
2 0 2 1 год хи рур г и ч е с к ое л еч е н и е H SI L .
П р едъ явл яет ж а л о б ы н а п е р и одич е ск ий зуд и
бел ы е г ус т ы е вы д ел ени я и з вл а га л ищ а.
П р а к т и к ует с а м ол еч ени е Фл ю к о назол ом в
д озе 1 5 0 м г / с ут ( п р и н им ает п о 1 - 2 - 3 к а п с ул ы
с и н те рвал о м 7 2 ч а с а ) .
Э ф ф е к т н е п ол ный .
47. Окончательный диагноз: «ЦИТОЛИТИЧЕСКИЙ ВАГИНОЗ»
Лечение зак лючается в«защелачивании» влагалищной
жидк ости;
К а к э то с д ел а т ь и н е а к т и в и р о ва т ь д ру г и е
у с л о в н о - п а т о г е н н ы е м и к р о о р г а н и зм ы , е с л и р Н
с та н е т б ол ь ш е 4 , 5 ?
Целес ообразно выявить и попытаться
устранить фак торы риск а;
К а к э то с д ел а т ь н е о тм е н я я К О К ?
48.
Лактобактерии в составе Дуожиналя, способныколонизировать вагинальную среду, оказывать ингибирующее действие
на патогены иактивировать иммунные реакции
1
Колонизация
вагинальной
среды3
Через 14 дней
2
Адгезия
к вагинальным
эпителиоцитам 1,3
3
Ингибирование
условно-патогенной
микрофлоры2
4
Активация местных и
системных иммунных
реакций1
В среднем за 12 часов
Ссылки: 1. Jang SE, Jeong JJ, Choi SY, Kim H, Han MJ, Kim DH (2017) Lactobacillusrhamnosus HN001 andLactobacillusacidophilus GLA-14 attenuateGardnerellavaginalisinfectedbacterialvaginosisinmice. Nutrients 9(6):23 2. LuciaBertuccini, RosarioRusso, Francesca Iosi1 andFabianaSuperti.
EffectsofLactobacillusrhamnosusandLactobacillusacidophilusonbacterialvaginalpathogens. InternationalJournalofImmunopathologyandPharmacology 1–5
3. DavideDeAlberti, RosarioRusso, FabioTerruzzi, VincenzoNobile, Arthur C. OuwehandLactobacillivaginalcolonisationafteroralconsumptionofRespectacomplex: a
randomisedcontrolledpilotstudyArchGynecolObstet (2015) 292:861–867 DOI 10.1007/s00404-015-3711-4
49.
Лактобактерии, входящие в состав Дуожиналь, способствуют полной элиминации условно-патогенных энтеробактерий (кишечных патогенов)
K.oxytoca
острый гастрит или гастродуоденит,
антибиотик-ассоциированная диарея
(ААД)
K .pneumoniae
Дисбактериоз кишечника и ААД
Enterobacter
asburae
Пищевые токсикоинфекции, дисбактериоз
Proteus mirabilis
Гастроэнтерит, колиэнтерит
E. Coli
Дисбактериоз кишечника, уретриты,
цистит
S.agalactiae
Колонизирует УГТ, риск ПР,
хорионамниониты, осложнения после КС,
сепсис у новорожденного
Citrobacter freundii
Гастроэнтериты, кишечные инфекции,
инфекции УГТ
C.albicans
РВВК, осложнения бер-ти, хориоамнионит,
ААД
Всего в исследование включены
одиннадцать клинических изолятов:
Escherichia coli (2 изолята), Klebsiella
pneumoniae, Klebsiella oxytoca, Enterobacter
asburae, Proteus mirabilis, Citrobacter freundii,
Staphylococcus aureus, Enterococcus faecalis,
Streptococcus agalactiae и Candida albicans
Будиловская О.В., Спасибова Е.В., Шалепо К.В., Хуснутдинова Т.А., Крысанова А.А., Синякова А.А., Беспалова О.Н., Савичева А.М. Антагонистическая и антибактериальная активность
Lactobacillus rhamnosus HN001 и Lactobacillus acidophilus La-14, входящих в состав Дуожиналь® // Журнал акушерства и женских болезней. 2024. Т. 73. № 3. С. 27–39. DOI:
https://doi.org/10.17816/JOWD630698
50.
Результаты совместного культивирования C.albicansи лактобацилл, входящих в состав препарата Дуожиналь®
C.albicans
на хромогенном агаре
Рост C.albicans и лактобацилл при совместном
культивировании с одним из штаммов лактобацилл
и подавление роста дрожжеподобных грибов
при внесении двух штаммов одновременно
Будиловская О.В., Спасибова Е.В., Шалепо К.В., Хуснутдинова Т.А., Крысанова А.А., Синякова А.А., Беспалова О.Н., Савичева А.М. Антагонистическая
и антибактериальная активность Lactobacillus rhamnosus HN001 и Lactobacillus acidophilus La-14, входящих в состав Дуожиналь® // Журнал акушерства и женских болезней. 2024. Т.
73. № 3. С. 27–39. DOI: https://doi.org/10.17816/JOWD630698
51.
Исследование чувствительности пробиотических штаммов лактобацилл,входящих в состав препарата Дуожиналь® (Lactobacillus rhamnosus HN001 и Lactobacillus
acidophilus La-14) к антимикробным препаратам (АМП)
Gram-positive AST (AutoBio, Китай)
Лактобактерии Дуожиналя устойчивы к
противомикробным препаратам различного
спектра действия
Будиловская О.В., Спасибова Е.В., Шалепо К.В., Хуснутдинова Т.А., Крысанова А.А., Синякова А.А., Беспалова О.Н., Савичева А.М. Антагонистическая
и антибактериальная активность Lactobacillus rhamnosus HN001 и Lactobacillus acidophilus La-14, входящих в состав Дуожиналь® // Журнал акушерства и женских болезней.
2024. Т. 73. № 3. С. 27–39. DOI: https://doi.org/10.17816/JOWD630698
52.
Инструкция (информация)по применению биологически активной добавки к пище Дуожиналь®
(обновления 2025 г)
Лактобактерии могут использоваться для восстановления и поддержания нормальной
микрофлоры, pH влагалища и кишечника, а также для восстановления местного иммунитета
при следующих состояниях:
при дисбактериозах кишечника различной этиологии, острых кишечных
инфекциях;
хронических колитах различной этиологии (в т.ч. неспецифический язвенный
колит), воспалительных заболеваниях желудка
и двенадцатиперстной кишки (в т.ч. связанных с присутствием Helicobacter pylori);
профилактике острых и хронических заболеваний ЖКТ;
истощающих болезнях и длительном стрессе;
предрасположенности к аллергическим состояниям;
оперативных вмешательствах на органах ЖКТ (пре- и послеоперационный период);
53. Дуожиналь имеет преимущества по сравнению с другими пероральными пробиотиками
Применение пробиотика Дуожиналь®Листок-вкладыш к БАД Дуожиналь
54.
Крем с ацидофильными лактобактериями и «суперлимфлайф» для интимной гигиеныhttps://www.rlsnet.ru/taa/acilakt-duo-krem-dlya-intimnoi-gigieny-dozirovannyi-86883
55. Пациентка 22 лет с рецидивирующим бактериальным вагинозом
Август 2025 года жалоб нетВ анамнезе бактериальный вагиноз
56. Вопросы по лечению
Как назначение Цифрана ® помогает справиться с бак териальнымвагинозом?
Почему в нарушение инструкции препарата уменьшается к урс лечения
влагалищными формами?
Возможно ли использование влагалищной формы ГЕКСИКОН ® в период
менструации?
Почему не назначен 2 этап для восстановления микрофлоры влагалища?
57. Препараты для лечения воспалительных и дисбиотических заболеваний влагалища
Широкий спектрдействия
Антисептики и НПВС
Гайномакс®
(тинидазол+тиоконазол)
Макмирор-комплекс ®
Полижинакс ®
Широкий спектр
действия с ГКС
Клиндацин Б пролонг®
(клиндамицин+бутоконазол)
Тержинан®
Эльжина®
Таржифорт®
Нео-пенотран®
Клион-Д®
Гиналгин®
Метрогил плюс®
Флуомизин®
Мирамистин®
Бетадин®
Гексикон®
Тантум роза®
Слабоактивны в
отношении Граэробов
РЛС

medicine
medicine








